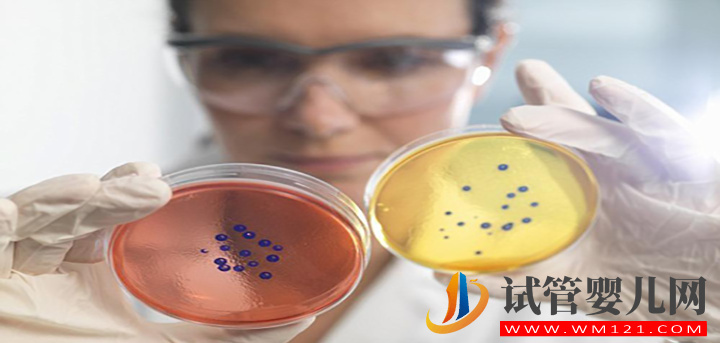
影響柬埔寨試管費用的3大因素，提前了解避免破費(圖1)

?
风间由美一区二区av101|
国产精品久久久久9999高清|
国产欧美一区二区三区四区|
在线观看精品视频看看播放|
国产麻豆精品在线观看|
国产免费黄色小视频|
aaa在线观看|
日韩一区二区电影网|
国产真实的和子乱拍在线观看|
精品国产91久久久久久浪潮蜜月|
国产日韩精品综合网站|
免费看美剧网站|
最新国产精品久久精品|
久久久无码人妻精品无码|
日本精品裸体写真集在线观看|
久久久国产成人精品|
婷婷丁香一区二区三区|
国产精品456|
日韩在线xxx|
大菠萝精品导航|
中日韩美女免费视频网站在线观看|
国产精品一区二区三区在线免费观看
|
成人信息集中地欧美|
黄色毛片在线|
一区二区三区精品久久久|
a毛片毛片av永久免费|
久久超级碰碰|
92国产精品久久久久首页|
av先锋影音少妇|
亚洲高清在线精品|
国产又黄又粗又猛又爽的|
欧美色网址大全|
国产精品久久久久久久免费大片
|
亚洲欧美精品在线|
av免费在线不卡|
国产一区二区三区综合|
又色又爽又高潮免费视频国产|
中文在线8资源库|
欧美成年人视频网站|
久久午夜宅男免费网站|
久久精品一级爱片|
成人在线电影网站|
麻豆精品av|
999热视频在线观看|
在线视频99|
欧美精品电影在线播放|
午夜精品久久久久久久蜜桃|
日韩精品一级二级|
国模吧无码一区二区三区|
欧美aa视频|
97在线视频免费观看|
日本免费黄网站|
亚洲国产成人精品视频|
欧美做爰爽爽爽爽爽爽|
精品91在线|
毛片在线视频观看|
成年女人在线看片|
久久久久久美女|
人与牲动交xxxbbb|
欧美午夜激情在线|
69国产精品视频免费观看|
日本91福利区|
91国产精品视频在线观看|
日韩毛片网站|
91色p视频在线|
最新天堂资源在线|
亚洲国产精品久久|
无码精品人妻一区二区|
欧美激情一区在线观看|
99久久久无码国产精品衣服|
久久久久国产|
国产盗摄视频在线观看|
bl视频在线免费观看|
欧美精品videossex性护士|
免费看h片网站|
91成人在线精品|
天天天天天天天干|
东方aⅴ免费观看久久av|
特黄特色免费视频|
精品视频99|
一区二区三区四区国产|
91av久久|
日韩免费观看网站|
日本韩国福利视频|
亚洲国产另类久久精品|
午夜性爽视频男人的天堂|
中文字幕一区二区三|
欧美黄色aaa|
日韩高清在线观看|
www.午夜av|
国产精品欧美日韩一区|
亚洲一区二区在线观|
黄色aa久久|
国产精品免费视频xxxx|
在线理论视频|
一区二区三区回区在观看免费视频|
欧洲精品乱码久久久久蜜桃|
亚洲不卡一区二区三区|
国产一级片免费在线观看|
成人毛片视频在线观看|
久操视频免费看|
亚洲国产一区二区精品专区|
欧美黄网站在线观看|
都市激情久久|
日韩高清dvd|
日韩精品极品|
国产原创欧美精品|
а天堂8中文最新版在线官网|
久久精品99久久久香蕉|
www.色婷婷|
欧美videossexotv100|
成年男人的天堂|
婷婷久久综合九色国产成人|
精品久久久久久久久久久国产字幕|
懂色av一区二区三区免费看|
娇妻被老王脔到高潮失禁视频|
亚洲自拍另类|
日韩av片免费观看|
91欧美大片|
精品国产免费av|
精品视频高潮|
26uuu成人|
亚洲毛片在线免费|
久久国产精品免费一区|
aa国产成人|
91免费欧美精品|
成人在线播放免费观看|
国产成人精品久久|
欧美色图另类|
欧美精品www|
宅男视频免费在线观看视频|
久久在线观看视频|
伦理电影国产精品|
色诱女教师一区二区三区|
先锋影音在av资源看片|
日韩电影免费在线观看中文字幕|
国产成人夜间影院在线观看|
91精品国产一区二区三区|
亚洲区精品久久一区二区三区
|
日本免费不卡一区二区|
国产一级成人av|
男女啪啪免费观看|
一区二区免费|
中文字幕av日韩精品|
99精品在线免费观看|
日韩精品国内|
伊人久久一区|
中文字幕精品—区二区日日骚|
成人午夜888|
亚洲综合av一区|
成人黄色91|
一区二区三区四区不卡|
999精品视频在线观看|
亚洲草草视频|
精品三级国产|
五月天激情图片|
牛牛影视一区二区三区免费看|
国产91在线亚洲|
日本韩国欧美超级黄在线观看|
人人妻人人澡人人爽欧美一区|
欧美日韩看看2015永久免费
|
日日日日影院|
亚洲精品中文字幕女同|
天天摸天天干|
色哟哟入口国产精品|
特级毛片在线观看|
欧美激情综合色|
国产九色在线|
国产精品久久色|
97超碰在线公开在线看免费|
91久久久国产精品|
性爽视频在线|
日本中文不卡|
粉嫩精品导航导航|
成年人视频观看|
国产精品99久久精品|
亚洲黄色片免费|
欧美亚洲在线|
亚洲精品国产精品国自|
成人免费高清在线|
毛片视频网站在线观看|
亚洲同性gay激情无套|
亚洲AV无码成人片在线观看
|
97视频在线观看网址|
91在线网址|
国产在线高清精品|
中文不卡1区2区3区|
色噜噜色狠狠狠狠狠综合色一|
亚洲一区二区三区在线免费|
国产极品在线视频|
自拍欧美日韩|
久久久久麻豆v国产精华液好用吗|
精品一区二区在线免费观看|
欧美成人一区二区三区高清|
中文字幕免费不卡在线|
99久久亚洲精品日本无码|
色综合久久久久久久|
欧美性xxxx极品hd欧美|
日韩av影视在线|
欧美aaa一级|
91精品国产99|
国产理论电影在线|
日韩av高清在线播放|
欧美一级色片|
亚洲一区二区在线视频观看|
天堂在线一区二区|
午夜69成人做爰视频|
国产精品福利电影一区二区三区四区|
www.五月激情|
日韩午夜在线影院|
国产一级粉嫩xxxx|
亲爱的老师9免费观看全集电视剧|
av丝袜在线|
亚洲欧美日韩国产成人综合一二三区
|
国产黄色一区|
www.av片|
亚洲激情综合|
久久国产波多野结衣|
国产视频亚洲色图|
国精品人妻无码一区二区三区喝尿
|
国产女18毛片多18精品|
欧美日韩亚洲综合在线|
成年女人毛片|
97热在线精品视频在线观看|
tube8在线hd|
女女同性女同一区二区三区按摩|
久久亚洲专区|
91网站免费视频|
国产亚洲人成网站|
午夜小视频在线播放|
日韩精品视频中文在线观看|
头脑特工队2免费完整版在线观看|
成人欧美一区二区三区黑人|
一区在线不卡|
性生活免费在线观看|
久久99国产精品成人|
男人天堂av在线播放|
在线免费观看日本一区|
天天操夜夜操天天射|
青青草99啪国产免费|
户外露出一区二区三区|
www.av毛片|
免费看黄裸体一级大秀欧美|
亚洲欧美在线视频免费|
欧美视频中文在线看|
成年女人在线视频|
欧美在线视频一区|
成人在线免费电影网站|
激情网站五月天|
久久av资源站|
91成人在线观看喷潮蘑菇|
99re热视频精品|
欧美一级特黄aaaaaa|
亚洲欧美国产精品专区久久
|
久久人妻无码一区二区|
亚洲激情婷婷|
精品无码免费视频|
91福利在线播放|
美女黄a一级视频|
亚洲伊人久久综合|
麻豆成人入口|
久久精品成人av|
亚洲天堂a在线|
曰皮视频在线播放免费的|
97精品国产97久久久久久免费
|
欧美私人免费视频|
日日噜噜夜夜狠狠视频|
俄罗斯精品一区二区|
九九久久婷婷|
亚洲一二三精品|
亚洲国产成人av网|
blackedav金发美女大战黑人|
国产精品久久久久久久久久99|
日韩一二三区|
国产xxxx视频|
●精品国产综合乱码久久久久|
在线免费电影观看|
日韩女优人人人人射在线视频|
久久精品免视看国产成人|
中文字幕一区二区三区人妻在线视频
|
av女人的天堂|
一区二区三区中文字幕精品精品|
两个人日本在线观看视频|
国产精品久久久久av免费|
一区二区精彩视频|
极品人妻一区二区三区|
日韩理论片在线|
xxx免费视频观看|
91久久综合亚洲鲁鲁五月天|
私拍精品福利视频在线一区|
久久久久无码精品国产sm果冻|
亚洲一区在线视频观看|
91九色porny视频|
国产精品手机在线|
亚洲电影在线一区二区三区|
亚洲精品在线观看av|
91精品欧美一区二区三区综合在|
免费在线看v|
可以免费看的黄色网址|
青青草国产成人99久久|
国产高清免费在线观看|
丝袜情趣国产精品|
日本成人片在线|
老司机av网站|
日韩理论在线观看|
free性亚洲|
久久一区二区精品|
夜夜精品视频|
国产精品探花视频|
日韩一区二区av|
不卡亚洲精品|
西西大胆午夜视频|
性久久久久久久久久久久|
宅男深夜国产|
自拍偷拍99|
经典一区二区三区|
中文字幕第一页在线|
欧美一区二区三区爱爱|
在线观看麻豆|
女人扒开屁股爽桶30分钟|
99国产精品久久久久|
国产精品视频白浆合集|
91精品久久久久久综合乱菊|
久久神马影院|
无码人妻一区二区三区免费|
精品视频久久久久久久|
亚洲同志男男gay1069网站|
中文字幕乱码在线人视频|
亚洲另类一区二区|
婷婷六月天丁香|
日本三级福利片|
国产精品一区二区在线观看网站|
性欧美free|
国产精品免费一区二区三区都可以
|
免费黄网大全|
国内一区二区三区在线视频|
国产精品久久久久久久久久妞妞
|
黄色高清在线观看|
日本女人高潮视频|
国产99久久久久久免费看农村|
国产日韩网站|
成人18视频|
午夜亚洲激情|
五月天激情婷婷|
国产91九色视频|
国产精品国产一区|
在线视频欧美亚洲|
欧美日韩不卡合集视频|
久久丝袜视频|
国产成人精品a视频一区|
亚洲欧洲在线看|
www.久久久.com|
亚洲女人久久久|
欧美精品一区二区不卡|
不卡av影片|
xxx在线播放|
91精品国产色综合久久ai换脸|
精品一性一色一乱农村|
精品国产免费久久久久久婷婷|
偷窥少妇高潮呻吟av久久免费|
国产69精品久久app免费版|
黄色一级大片在线观看|
亚洲视频在线一区二区|
中文字幕在线观|
欧美 丝袜 自拍 制服 另类|
中文字幕国产一区二区|
成人福利视频导航|
国产91xxx|
国产精品国产自产拍高清av王其|
福利网址在线|
成人在线免费在线观看|
亚洲欧美日韩国产综合在线|
亚洲大胆精品|
一级黄色香蕉视频|
亚洲线精品一区二区三区|
国产在线观看精品一区|
999在线观看|
欧美午夜影院在线视频|
久久bbxx|
美女伦理水蜜桃4|
欧美视频在线播放|
不卡专区在线|
国产精品久久久久久久av|
亚洲成年人影院在线|
欧美91在线|欧美|
欧美三根一起进三p|
伊是香蕉大人久久|
六月丁香久久丫|
中文字幕av影视|
欧洲精品久久久|
亚洲国产裸拍裸体视频在线观看乱了中文
|
亚洲动漫第一页|
91在线中文|
蜜桃传媒一区二区亚洲av|
日韩女同互慰一区二区|
巨大黑人极品videos精品|
麻豆成人在线视频|
久久精品小视频|
成人中文在线|
日韩有码第一页|